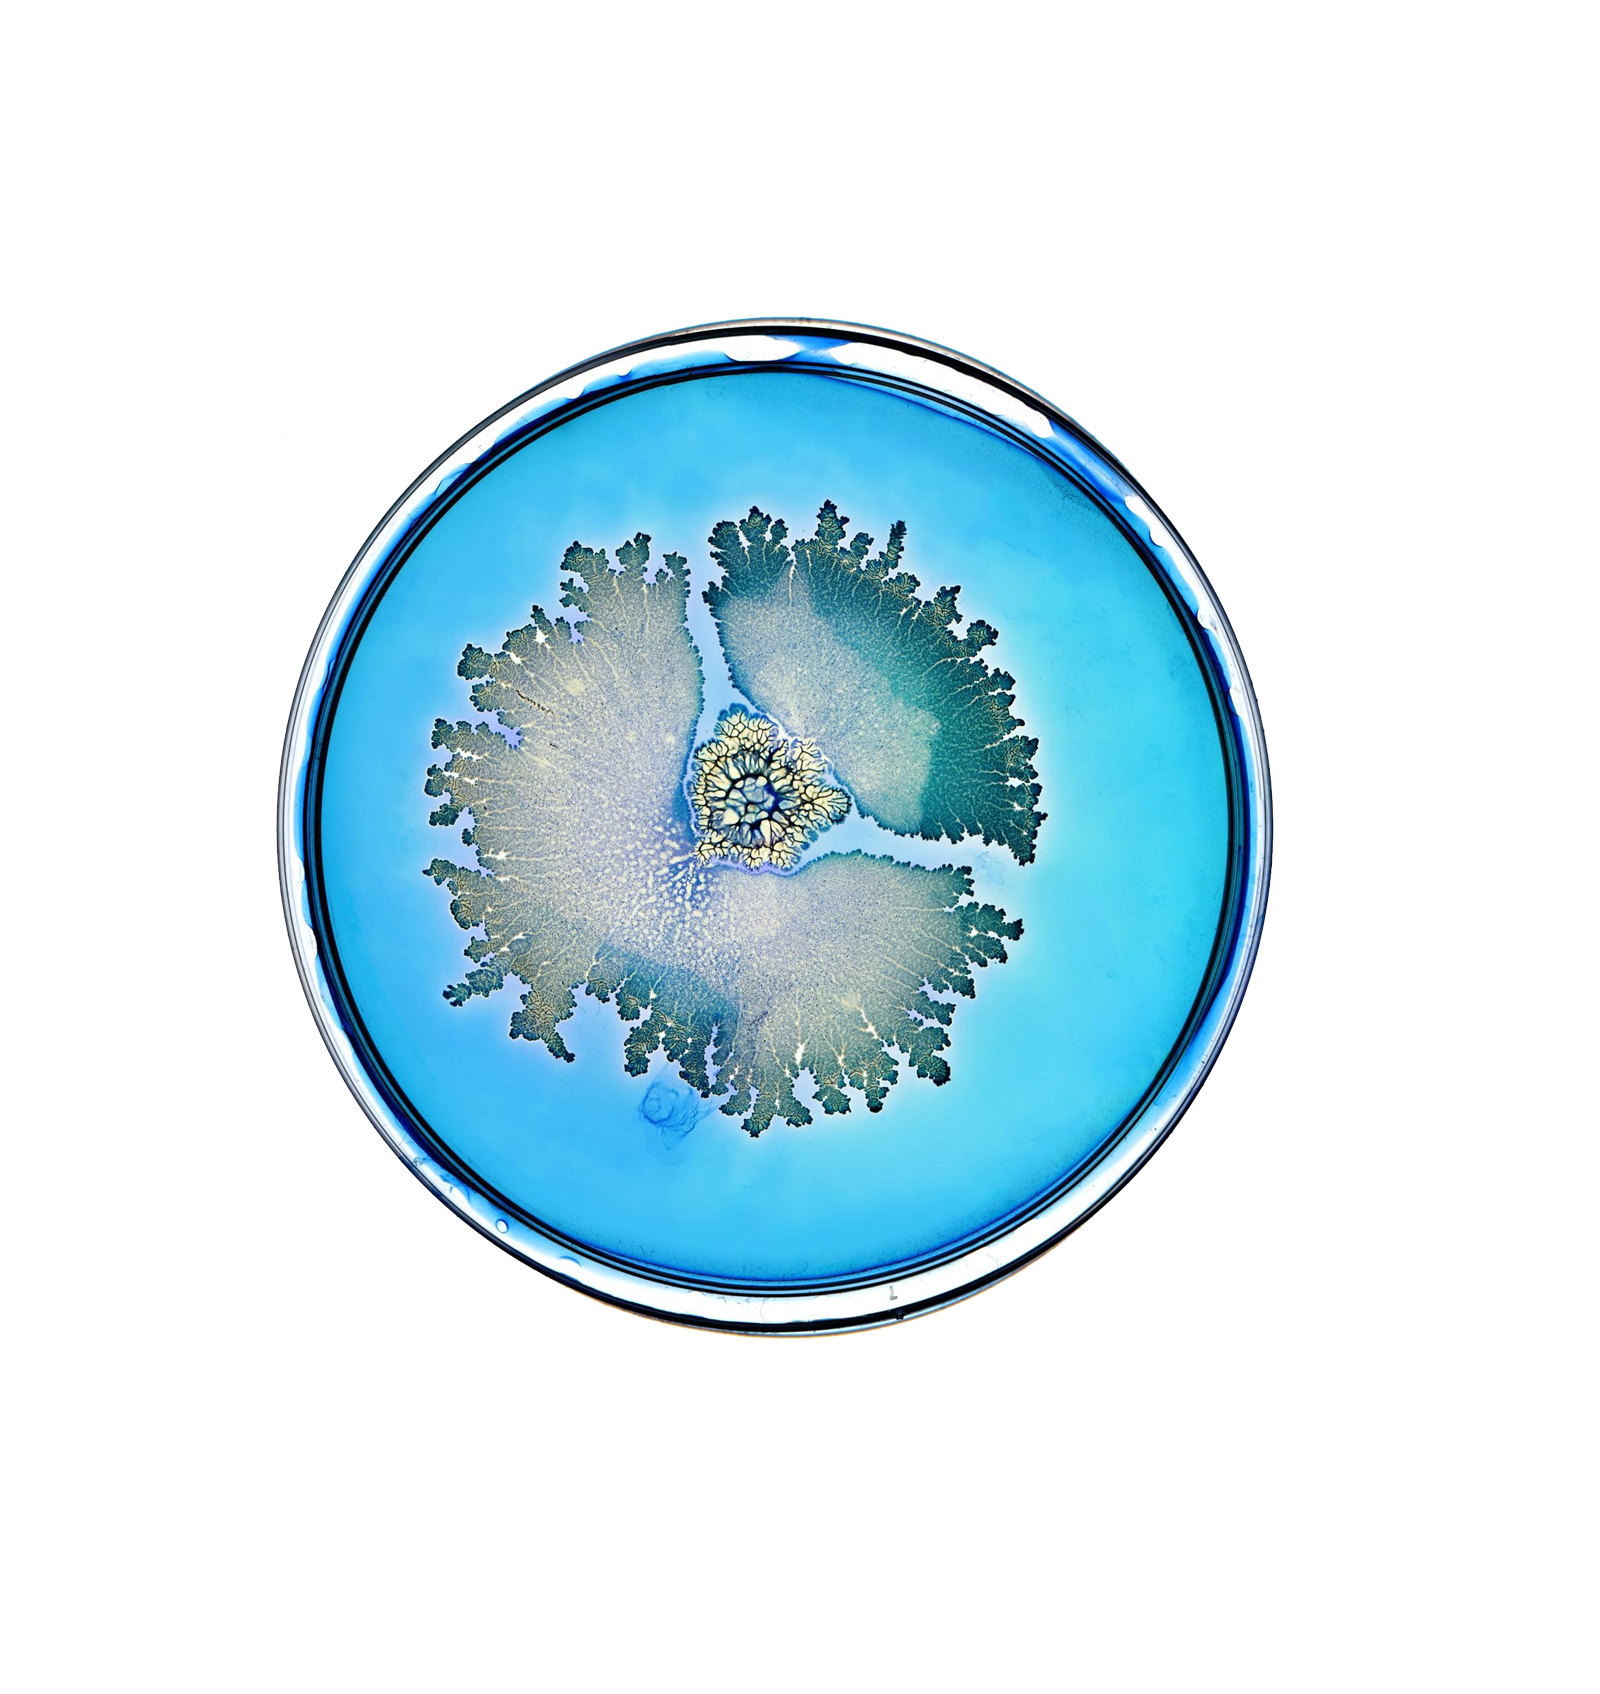
5

Seed x Erewhon
We're so excited to not only be the first retailer ever to carry Seed, but we've teamed up with them for an amazing microbiome supportive shot!
We're so excited to not only be the first retailer ever to carry Seed, but we've teamed up with them for an amazing microbiome supportive shot!
We sat down with the owner of Seed, Ara, to learn more about everything microbiome.

Erewhon: What exactly is a “microbiome”?
Ara: A Microbiome is a collection of microorganisms (aka microbiota) in a specific environment (your gut, for example). More specifically, a microbiome includes not only the microorganisms themself, but also their genes, structural elements, metabolites and surroundings—collectively forming a unique ecosystem.
Erewhon: Why is it important?
Ara: our microbes perform critical functions throughout your body, and thus your microbiome impacts your health in many ways.
To start, the microorganisms along your intestinal epithelial wall, due to sheer strength in numbers, protect your gut barrier integrity, making it difficult for inhospitable bacteria to penetrate. They help maintain an acidic environment to dissuade certain alkaline-loving pathogenic bacteria from taking root.
Your intestinal microbes also support the secretion of intestinal mucus and collaborate closely with your gut’s ‘gatekeepers’ (tight junctions) to modulate what should (ie. nutrients) or shouldn’t (ie. undigested food particles or pathogenic bacteria) pass through to the body. Certain bacteria even produce neurotransmitters that stimulate muscle contractions—yes, we’re talking about poops.
Gut bacteria also help us digest food, synthesize key vitamins and nutrients, metabolites, and even play a role in managing immune responses.
There are microbiomes that exist outside the gut as well—your armpits, skin, genitals, and even your lungs, each with their own unique characteristics and functions.
Though invisible to the naked eye, their impact is far from unnoticed. Referred to by scientists as your ‘lost organ’, and even your ‘second’ brain—these are the communities of microorganisms that live in and on you. There is almost no function in the human body in which microbes are not connected too—new findings emerge constantly illuminating various associations between our microbiome(s) and our bodies.
These revelations are redefining health and radically transforming the way we approach medicine, hygiene, diet, living, and the choices we make for ourselves, our children, and our planet. It’s also revealing the vast potential of microbes (and probiotics) to impact our lives.
E: Where does it come from?
A: The first microbes you’re exposed to are your mother’s—through birth, skin-to-skin contact, and breastfeeding. This colonization of the gastrointestinal tract is a process called seeding. It begins during birth and continues through early infant and child development, until it reaches a more steady state between ages 3-5.
Many factors influence the development of the early microbiome including—birthing mode (vaginal versus cesarean birth), exposure to antibiotics, breastfeeding patterns, environment, and early nutrition.
Seeding continues to be influenced by the environment you’re born into. Nature, nutrition, family members, and even pets, can all contribute to your microbial mosaic.Between the ages of 3-5, your microbiome stabilizes into what’s called your steady state microbiome. External factors like diet, exercise, medicine, and sleep will continue to alter the composition for the rest of your life, but your dominant species should remain relatively unchanged, especially if you treat them well.All said, seeding is an essential part of your early biological development, impacting overall health.

E: Is it true we are more microbiome than human? Can you explain?
A: You are home to trillions of microorganisms, including 38,000,000,000,000 bacteria that live in and on you. The bacteria part alone represents approximately 50% of you by cell count. And while there aren’t definitive estimates for the number of viral, fungal, and/or other microbes in and on your body, this is likely in the trillions! Where we once thought ourselves fully human, we now know we are, in fact, walking talking ecosystems—in science, we are referred to as ‘superorganisms’’.
E: Is the microbiome only in your gut?
A: Although the gut microbiome is the most abundant microbiome of the body, microbes do reside in many other places like your mouth, your skin, your genitals and your armpits, etc., each with their own unique microbiome and functions.
In fact, new research is beginning to uncover distinct microbiomes of organs which we once thought were sterile—such as the lung, breast, and eye.
E: What role does the microbiome play in:A: As mentioned, there is almost no function in the human body that your microbes aren’t involved in. You can think of the gut microbiome in particular, as the switchboard of communication for many other body systems. The bi-directional communication between these systems is often dubbed the “gut-X-axis”–for example, the gut-skin-axis, gut-immune-axis, and gut-brain-axis. It is within these axes that our microbes can impact our immune, mental and skin health.
Enterocytes (gut cells) can communicate with the immune, skin and nervous systems through various metabolites, pathways, hormones, chemical messengers.
For example,
in the gut produces specific metabolites that can modulate stress and directly link to the immune system, which then influences the balance of the neurotransmitters that work in the brain—ultimately impacting mental health and behavior.As another example, via the gut-skin-axis, gut microbes can affect skin health through various pathways and mechanisms. Certain gut metabolites can promote the accumulation of specialized immune cells (regulatory T cells and lymphocytes) which facilitate anti-inflammatory responses in the skin.
E: What is the difference between a pre, pro, and postbiotic?
A: Though the names are quite similar, there are important differences between prebiotics, probiotics, and postbiotics. Let’s start with the definitions—
The International Scientific Association for Probiotics and Prebiotics (ISAPP) defines them as the following:
Prebiotic: “A substrate that is selectively utilized by host microorganisms conferring a health benefit“a substrate that is selectively utilized by host microorganisms conferring a health benefit.”
Probiotic: “Live microorganisms that, when administered in adequate amounts, confer a health benefit on the host.”
Postbiotic: “A preparation of inanimate microorganisms and/or their components that confers a health benefit on the host.”
Prebiotics are not microorganisms, but are compounds that are used by microbes in some way that is beneficial to the host, or human body. These are often plant compounds such as certain fibers or polyphenols, though can also be compounds like human milk oligosaccharides (HMOs) found in breast milk.
Probiotics are live microorganisms that provide a health benefit, whereas postbiotics are inactive, dead or components of microorganisms that provide a health benefit.
E: Is a person’s microbiome unique to them?
A: Like your genome or your fingerprint, your microbiome is completely unique to you—the kaleidoscope of microbes that you harbor cannot be found anywhere else on Earth. What’s more—it’s changing, constantly. External factors such as diet, exercise, medicine, and even sleep can all impact and alter the composition of your microbiome on a daily basis.
Imagine Earth’s ecosystems as an analogy of your own inner world. Over days and weeks and seasons and years, there may be different kinds of trees or plants or animals in different forests and deserts and oceans. But the ecological functions that make up that forest and keep each ecosystem thriving are continuous and conserved. In other words, our microbiomes are all vastly different from one another, but the functions they maintain for our health are relatively similar. Whatever microbes exist within us, they’ve evolved to be there.
E: How do I know which probiotic I should take to support my microbiome?
A: Before choosing a probiotic, it’s important to understand not all ‘probiotics’ are actually probiotics and we need to align around how the term ‘probiotic’ is defined. Commercial probiotics vary widely in regards to strains, dosages and delivery systems, all of which may impact the amount of live bacteria that is ultimately consumed and delivered to the intestines, which impacts any potential effects.
This is why we always recommend that you ask 3 important questions when choosing a probiotic (including ours):
Whatever probiotic you go with must meet the globally-accepted, scientific definition of probiotics: ‘live microorganisms which, when administered in adequate amounts, confer a health benefit on the host’ (authored by a joint United Nations - World Health Organization Expert Panel chaired by our Chief Scientist, Dr. Gregor Reid, in 2002).

E: What is the latest thing you have learned about the microbiome?
A: Just like you and me, coral has its own microbiome—a unique set of microorganisms that contribute to the health of the greater whole of the animal. And, like humans, this community of microbes develops through the coral's lifespan until it reaches its own 'steady-state microbiome', with signs of host species specificity and, possibly, a core microbiome. Even more intriguing, there are inter-individual (between the same species) differences in microbiomes between corals similar to the microbiome of the human gut.
This microbial flora and fauna are also dependent on the environment in which corals are located. As they live in different oceanic environments—currents sway, storms rage, the surrounding microbial composition of the reefs may change—but the polyps themselves have a core community that exists within them.
The coral microbiome is responsible for several important
, including nutrient cycling, bio-mineralization for calcification and growth, breakdown of plant compounds such as DMSP, UV protection, biological control of microbial populations including pathogens and algal blooms, and the influence of larvae settlement and metamorphosis (aka the transition from free-floating offspring to budding reef-building polyp).The coral microbiome represents an exciting and fascinating new area of research for coral reef conservation and restoration, with deep implications on environmental health and ocean ecosystem stability.
E: What is still unknown about the microbiome?
A: Though we’ve learned a lot about the invisible world inside and around us, the conversation about microbes is truly just beginning—as technology progresses and the research expands, the potential for discovery is vast—not only for the fields of human health and medicine, but for our food, our homes, our cities, and as we think about finding solutions to some of our greatest environmental challenges.
This top of mind—we founded SeedLabs to develop novel applications of bacteria to enhance biodiversity and recover ecosystems impacted by human activity. One example of this—probiotics for honey bees.
SeedLab’s Chief Scientist, Dr. Gregor Reid, and SeedLabs Fellow, Brendan Daisley,
three probiotic strains—Lactobacillus plantarum Lp39, Lactobacillus rhamnosus GR-1, and Lactobacillus kunkeei BR-1—with the potential to improve innate immune response, provide resistance against infection, and reduce the use of toxic pesticides. So, we developed The BioPatty™, formulated with these three probiotic strains and delivered it to A. mellifera hives.On the human health front, the vaginal ecosystem is host to a diverse community of microorganisms that play a critical role in urogenital and reproductive health and differ in important ways from other microbiomes of the body. Despite this importance, there was an unmet need for a reference catalogue for the microbial communities that inhabit the vagina—a platform that would undoubtedly propel this area of research.
To meet this need, we announced
in Fall 2019 as the first biotechnology company to emerge from the Seed Health foundry. LUCA Biologics created the first comprehensive gene catalogue of the human vaginal microbiome and this information is guiding the development of a new class of living medicines targeting the vaginal microbiome—impacting reproductive and urogenital health. Our pipeline includes therapeutics for urinary tract infection (UTI), preterm birth (PTB), bacterial vaginosis (BV), and infertility.To summarize, microbiome science truly represents a new frontier, one that we’re thrilled to be at the forefront of. It’s connections to both human and environmental health are ever expanding, with boundless opportunities and potential.
E: What are some of the newest discoveries in science about the microbiome and how are they being applied to overall health?
A: Your body is complex and interconnected—and the gastrointestinal system sits at the core of it all. There's almost no function in the human body that microbes aren't involved in. New findings emerge constantly, illuminating the impact our gut flora may have on various facets of human health. Metabolites and byproducts produced by intestinal microbes can have a far-reaching impact.
For example, we now know that the gut communicates with the nervous system via a collection of pathways known as the
or linking emotional and cognitive centers of the brain with peripheral intestinal functions.Insights into the gut-brain crosstalk have revealed a complex communication system that not only allows the brain to influence intestinal activities (like gas and bloating), but enables the gut to affect mood disorders, cognition and neurological conditions.
in animals showed that behaviour is affected in the absence of certain microbiota, and that this behaviour altered after given specific strains of bacteria.Future studies will focus on understanding the mechanisms that underlie the microbiota-gut-brain axis in hopes of further elucidating microbial-based intervention and potential novel therapeutic strategies for many neuropsychiatric disorders.
About Ara:
Ara Katz is the Co-Founder and Co-CEO of Seed Health, a microbial sciences company pioneering the application of bacteria to impact human and planetary health. She is working to steward a new standard in probiotics and how science is communicated to change how we discern evidence from evangelism to make the most informed choices for our bodies, our health, and our world.
Ara has been a fellow at the MIT Media Lab’s Center for Future Storytelling and CCA’s Design MBA program, was named in Marie Claire’s “The New Guard: The 50 Most Influential Women in America”, listed on Business Insider’s “Silicon Alley Top 100” and “36 Rockstar Women in NYC Tech”, and Create + Cultivate’s 100 List for STEM.